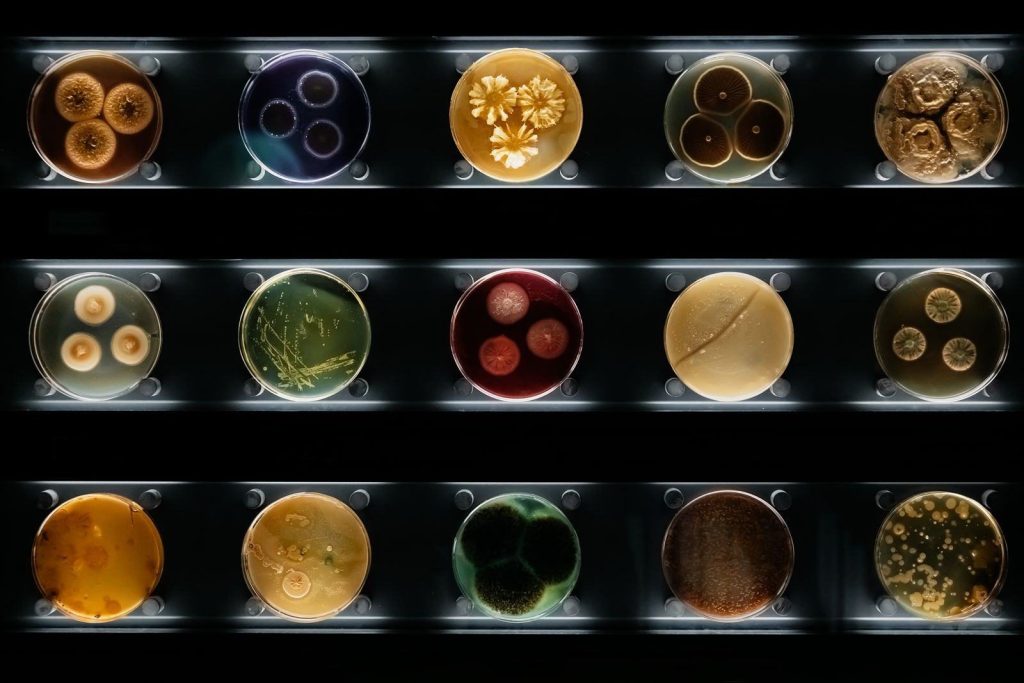

The answer is messier than we'd like. Your microbiome — that hidden civilization of bacteria, fungi, and archaea living inside you — isn't just along for the ride. It influences your cravings, mood, immune responses, even how you think.
And here's what makes this truly strange: the state of your inner ecosystem mirrors the state of the world you live in. Your gut is a living record of your culture's values, myths, and pathologies.
Modern life is rewriting your microbiome like a bad editor with a red pen. And your body is starting to notice.

The Microbiome as Mirror
Microbes respond to the same things humans do.
They thrive on diversity and collapse under monotony. They flourish in community and deteriorate in chaos. They love plant-rich environments and become anxious — yes, biologically anxious — under chronic stress.
This isn't metaphor. It's measurable biochemistry.
When your cortisol spikes, your gut bacteria register it. When you eat the same three foods on rotation, microbial species die off from lack of stimulation. When you're socially isolated, your microbiome becomes less diverse.
The parallel between human and microbial wellbeing is so precise it's almost eerie.
The microbiome doesn't just affect your health. It reflects it. Your choices, your environment, your culture's values — all of it shows up in your gut.
But the relationship runs both ways. That same ecosystem produces neurotransmitters that shape your mood, trains your immune system, affects which genes get expressed and which stay dormant.
Your microbes are not passengers. They're co-authors of your biology.
And right now, for most people in industrialized societies, that biology is telling a very specific story.
Your gut probably feels like what it is: a stressed-out, sleep-deprived, overcaffeinated city running on processed food. The microbial diversity collapsing inside you mirrors the biodiversity collapsing across the planet.
Certain bacterial strains dominate aggressively, pushing others out, until your inner ecology starts to resemble the political landscape outside — monopolized, inflamed, increasingly hostile to complexity.
How Culture Reshapes Your Inner Ecology
Most of what we crave isn't preference. It's bacterial lobbying.
Your microbes send chemical signals to your brain — "feed me sugar," "feed me fat," "feed me fiber." Which bacterial voices dominate depends on which species are still alive in your gut.
And here's where another variable enters the equation — one that influences not just what you eat, but how you eat, when you eat, even what eating means: culture.
For most of human history, cultures understood the body as something fundamentally wild. Your health depended on right relationship with plants, soil, seasons, microbes, community.
Food was ceremony. Bacteria were allies. Stress was temporary, tied to real threats, resolved through rest and ritual. The body was an ecology you belonged to, not a machine you operated.
Then came industrialization and a new story: the body as mechanism.
Medicine became mechanical intervention. Food became fuel input. Bacteria became enemy invaders. Productivity became virtue. Rest became weakness.
The goal shifted from harmony to control, from collaboration to optimization, from presence to performance.
This wasn't just philosophy. It was instructions that reached the cellular level.
Treat food as fuel and you determine which bacteria survive in your gut. Eat for speed and convenience, and you feed yourself informationally dead food that your microbes don't recognize.
The fiber-loving bacteria starve out. The sugar-dependent ones multiply. Your cravings intensify.
And it feels like personal preference when really you're just hearing the loudest voices in an increasingly impoverished ecosystem.
Declare war on bacteria and you reject wildness itself. A century of sterilizing and eliminating microbial exposure has destroyed the communities that trained our immune systems and produced our neurotransmitters.

The cost: your microbiome takes over two years to recover from a single course of antibiotics. Some bacterial species never return.
Studies comparing Western gut microbiomes with those of traditional hunter-gatherer groups show that industrialized populations have lost 30–50% of their microbial diversity[1, 2] — a decline linked to dietary shifts, reduced fiber intake, sanitation, antibiotics, and lifestyle changes.
Turn chronic stress into a status symbol and you send a biochemical message to your microbiome that the world is ending. Cortisol surges. Inflammation spikes. Microbial diversity collapses.
But society keeps rewarding the performance, so you keep pushing, and your gut keeps signaling distress that goes ignored.
All of this traces back to one shift: treating the body as machine rather than ecosystem. And your microbiome is paying the price for a story that your biology doesn't recognize.
Your Microbiome Is Biography, Not Just Biology
Every person's gut community is formed by where they live, what they eat, how they were raised, what they believe, how they cope with life, and what their culture taught them to value.
Which means researchers can now predict your likelihood of depression and anxiety just by analyzing your gut bacteria.
The relationship between microbiome and psychology isn't metaphorical. It's biochemical, bidirectional, and disturbingly precise. Your inner ecology doesn't just reflect your mental state. It shapes it.
Modern society values speed over presence, convenience over care, productivity over rest, profit over ecology, perfection over humanity.
These values create a microbiome shaped by inflammation, metabolic dysfunction, anxiety, decreased diversity, and pathogenic dominance.
Your outer world shapes your inner world. But the reverse matters too: a biodiverse, plant-fed microbiome supports clearer thinking, more balanced emotional responses, better mood, and stability.
Which means changing what you eat isn't just changing your health. It's changing your relationship with the world — from passive consumer of whatever industrial food systems produce to active participant in ecological relationships that predate those systems by millions of years.
You stop being someone culture feeds and become someone choosing which biological conversations to engage in.
And when you shift from consuming what's convenient to nourishing what's alive, you start changing which world you're participating in.
Plants as Ecological Correction
Veganism being good for the microbiome is not exactly breaking news. But we often present it in dull, technical terms — fiber counts, short-chain fatty acids, butyrate production, reduced inflammation.
The deeper truth is more interesting: a plant-based diet helps decolonize your microbiome from the myths of modern culture.
Every plant you eat introduces new fibers, polyphenols, and nutrients that different microbes feast on. Diversity in your diet translates to diversity in your microbiome, which translates to resilience.
This is why epidemiologists recommend eating thirty different plants per week. It's less nutrition advice, more ecological restoration.
A plant-rich gut isn't ruled by one or two bacterial tyrants. It becomes a multiparty system where cooperation trumps domination.
You can feel this internally as better digestion, more stable mood, sharper focus, reduced cravings, fewer inflammation spikes.
Your microbes recognize plants. They evolved with them. They read plants like ancient texts.
This recognition isn't just biochemical—it's a form of remembering. A plant-based diet reconnects your internal world to the external world's natural rhythms — something modern life has tried very hard to erase.
Plants also challenge the cultural story that health must be complicated. Your microbiome doesn't want fancy biohacks or elaborate protocols. It wants simplicity, diversity, and consistency. It wants real food from the earth.
Patterns Over Perfection
Here's the uncomfortable truth about changing your microbiome: there's no single moment of transformation. No clean break between "before" and "after." No magic threshold where you've officially decolonized your gut from industrial food culture.
What matters isn't purity. It's direction.
Your microbiome doesn't care if you had processed food yesterday. It cares whether you're feeding the same bacterial voices year after year or slowly shifting which species get amplified.
Every meal is a vote for which microbes survive, which messages get sent to your brain, which version of your biology gets expressed.
The question isn't whether you're perfect. It's whether you're moving toward relationships your body recognizes or continuing to participate in the ones culture sold you.
This is harder than it sounds, because culture doesn't just sell you bad food. It sells you the framework that makes changing feel impossible: the all-or-nothing thinking, the guilt, the idea that if you're not doing it perfectly you might as well not bother.
These are the same patterns that keep you consuming, keep you stressed, keep you treating your body like a machine that needs to perform rather than an ecology that needs to breathe.
Your microbiome is not judging you. It doesn't want your perfection. It wants your attention.
And attention, practiced consistently, eventually becomes transformation.
What Your Gut Is Trying to Tell You
Your microbiome isn't just biology. It's biography. It's a living archive of every choice, stress, meal, antibiotic, sleepless night, and moment of joy you've experienced.
It records what your culture values and what it destroys. It tells the truth when your mind is lying.
And right now? Most of our microbiomes are telling a story we don't want to hear.
They're saying: you're moving too fast. You're eating food that isn't food. You're living in ways your biology doesn't recognize. You're severed from the earth, from slowness, from the microbial community that made complex life possible in the first place.
A plant-based diet isn't just healthier in some abstract sense. It's an ecological correction.
It's what happens when you stop treating your body like a machine to be optimized and start treating it like an ecosystem to be nurtured. It diversifies your inner world. It restores relationships that industrialized food broke. It reconnects you to the plant kingdom that your microbes co-evolved with for millions of years.
But here's what no one wants to admit: you can eat all the fiber in the world and still be microbially poor if you're living a life that's fundamentally at war with your biology.
The microbiome doesn't just want plants. It wants rest, community, exposure to the natural world, slowness, presence.
It wants you to stop living like a machine.
Your gut is trying to tell you something. The question is whether you're ready to listen.
Footnotes:
1. Obregon-Tito et al., *Subsistence strategies in traditional societies distinguish gut microbiomes*, *Nature Communications* (2015). https://www.nature.com/articles/ncomms8505
2. Clemente et al., *The microbiome of uncontacted Amerindians*, *Science Advances* (2015). https://www.science.org/doi/pdf/10.1126/sciadv.1500183